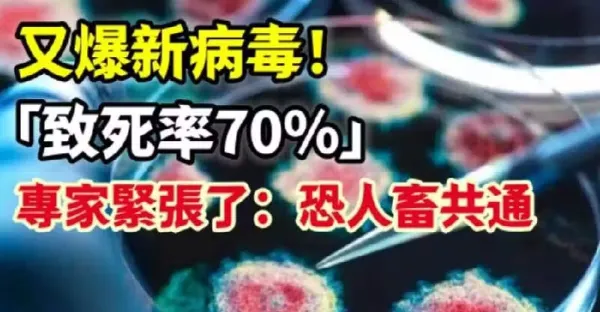

任紹昌 • 1K次觀看

呂純弘 • 3K次觀看

呂純弘 • 1K次觀看

奚芝厚 • 290次觀看

呂純弘 • 2K次觀看

花伊風 • 160次觀看

喬峰傳 • 660次觀看

劉奇奇 • 310次觀看

劉奇奇 • 380次觀看

徐程瀅 • 890次觀看

尚娥媛 • 730次觀看

奚芝厚 • 160次觀看

奚芝厚 • 320次觀看

喬峰傳 • 800次觀看

喬峰傳 • 2K次觀看

呂純弘 • 150次觀看

任紹昌 • 370次觀看

喬峰傳 • 120次觀看

喬峰傳 • 520次觀看

任紹昌 • 850次觀看

呂純弘 • 3K次觀看

劉奇奇 • 270次觀看

劉奇奇 • 760次觀看

許夢可 • 2K次觀看